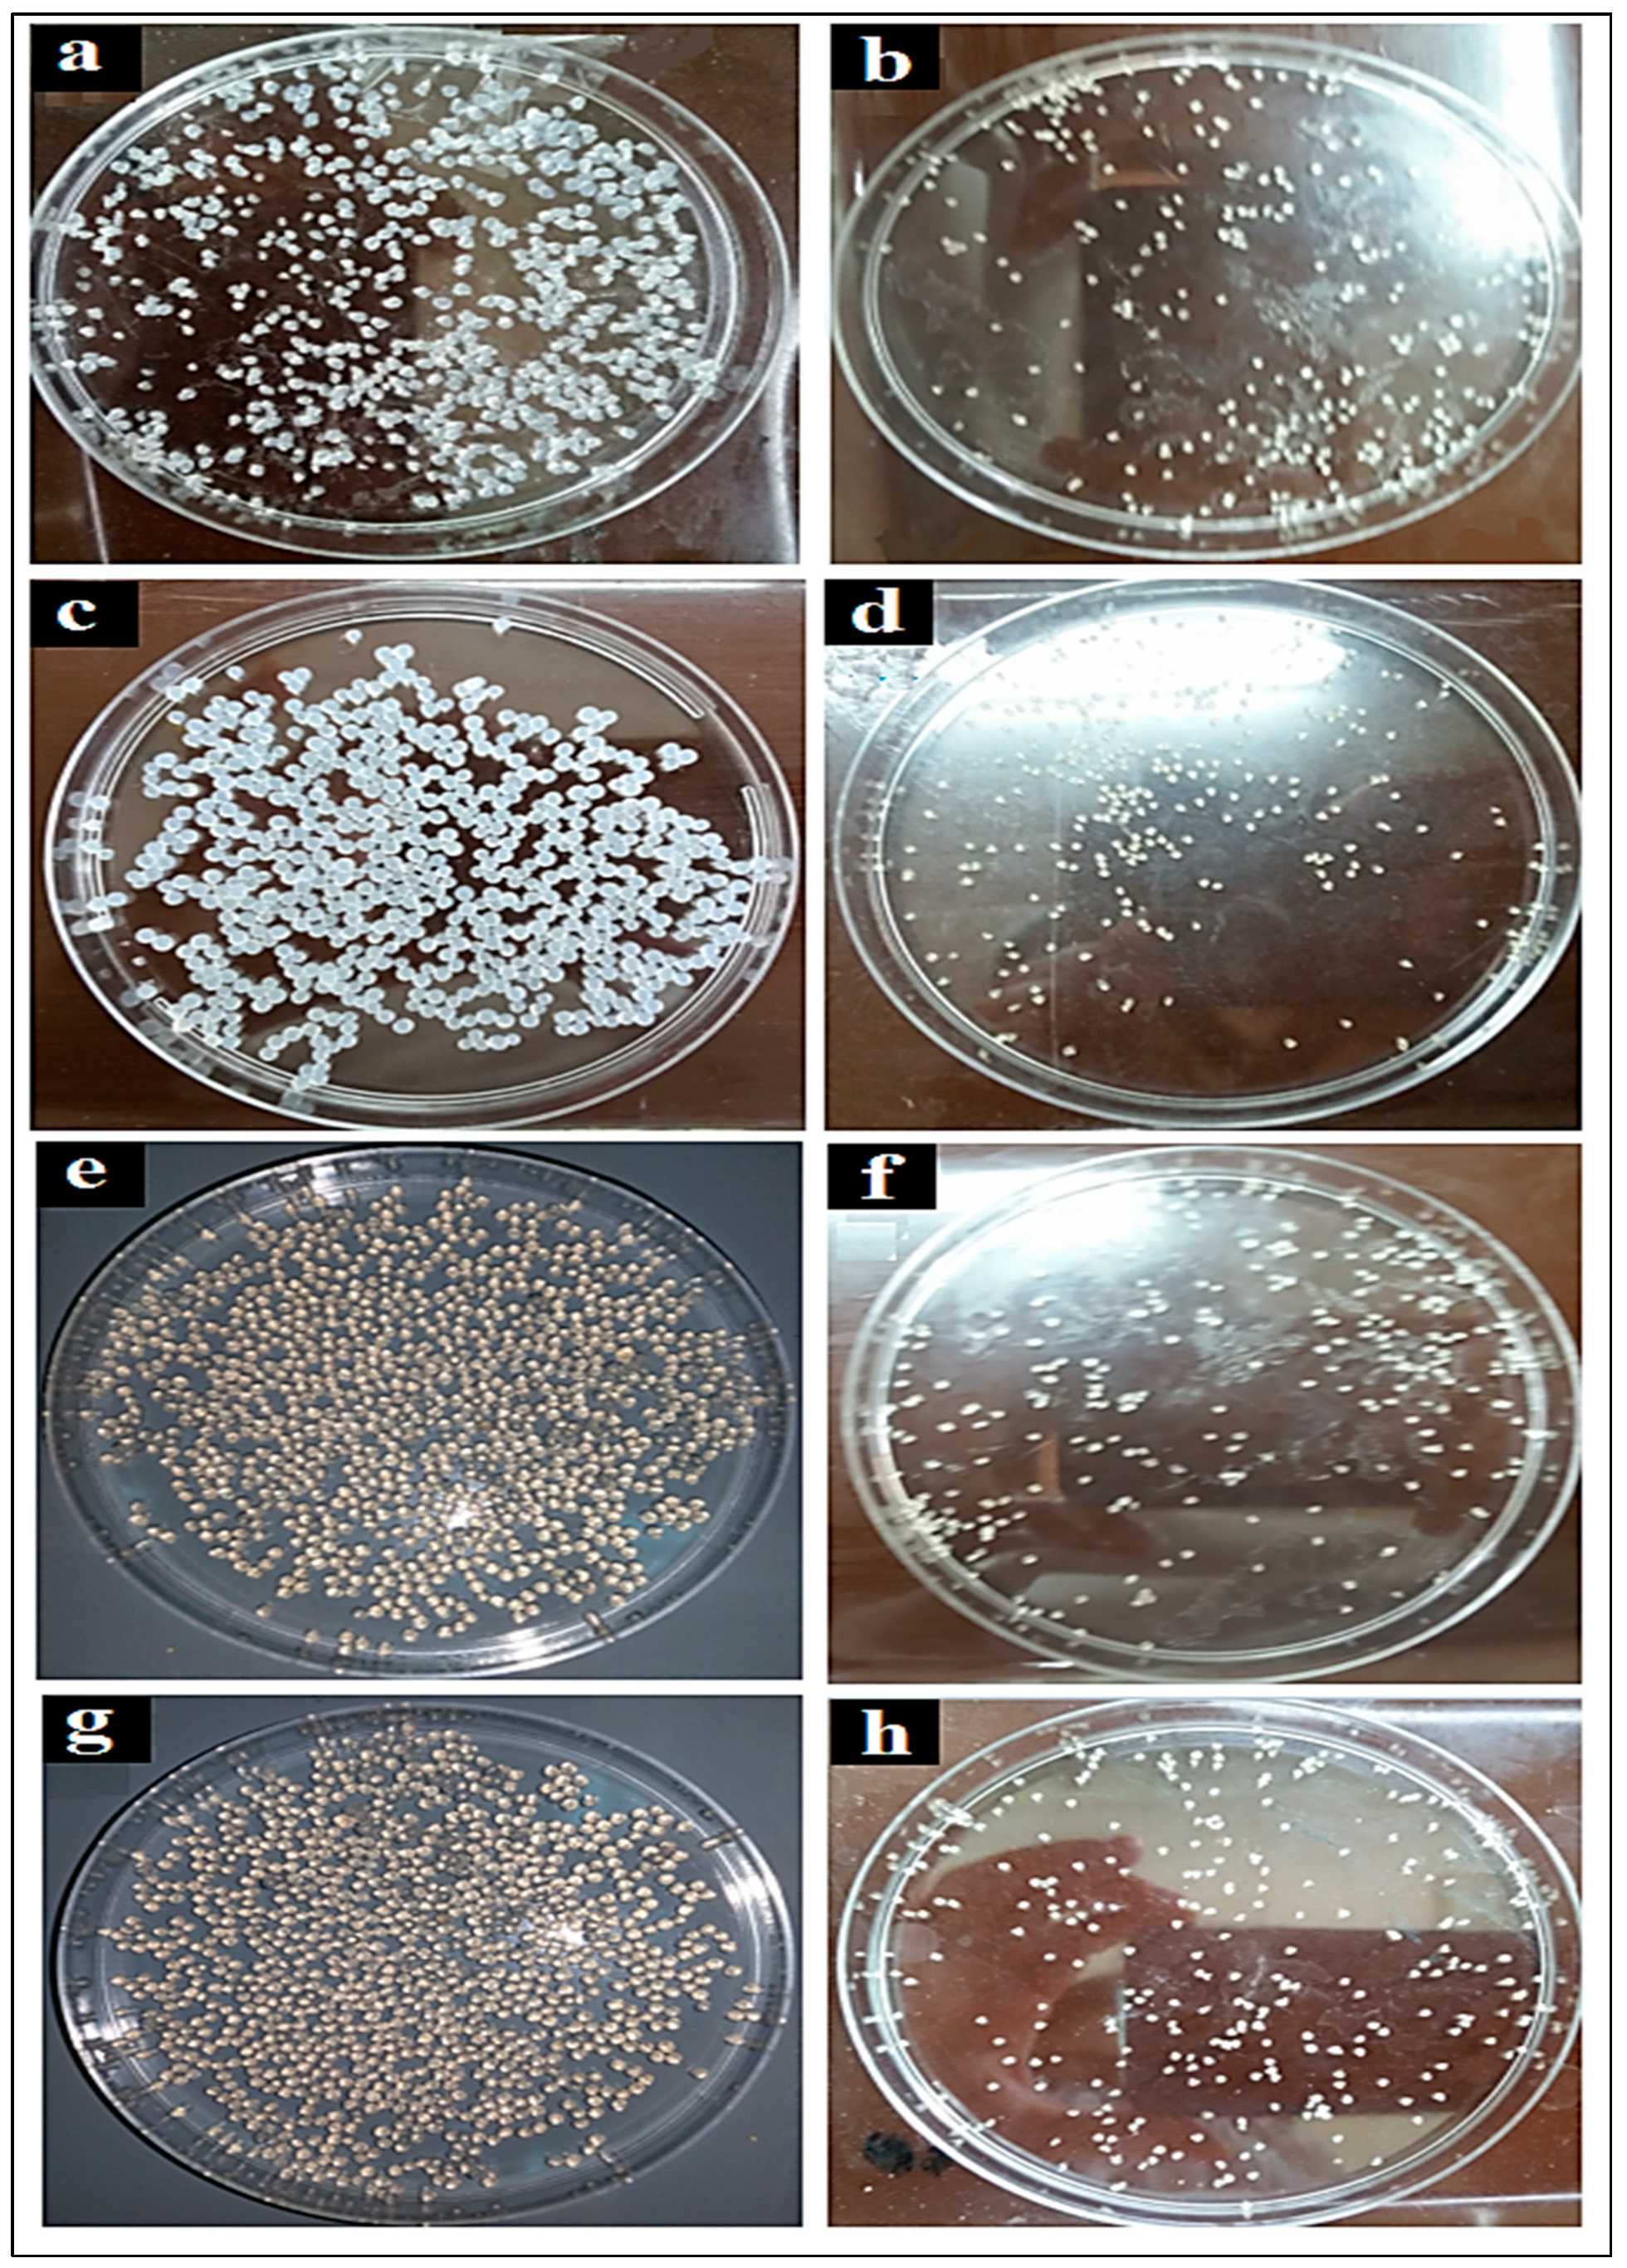

Formulation and Evaluation of Xanthan Gum Microspheres for the Sustained Release of Metformin Hydrochloride
Abstract
1. Introduction
2. Materials and Methods
2.1. Materials
2.2. Fourier Transform Infrared (FTIR) Analysis
2.3. Viscosity Measurement of Xanthan Gum Hydrogels
2.4. Formulation and Characterization of MTH Microparticles
2.5. Particle Size Measurement
2.6. Swelling Study of MTH Microparticles
2.7. Encapsulation Efficiency
2.8. Calibration Curve
2.9. In Vitro Release Study
2.10. Statistical Analysis
3. Results and Discussion
3.1. Fourier Transform Infrared (FTIR) Analysis
3.2. Viscosity Measurement of Xanthan Gum Hydrogels
3.3. Particle Size Measurement
3.4. Swelling Study
3.5. Entrapment Efficiency
3.6. Calibration Curve
3.7. In Vitro Release Study
4. Conclusions
Author Contributions
Funding
Data Availability Statement
Conflicts of Interest
References
- Yahoum, M.M.; Lefnaoui, S.; Moulai-Mostefa, N. Design and Evaluation of Sustained Release Hydrophilic Matrix Tablets of Piroxicam Based on Carboxymethyl Xanthan Derivatives. Soft Mater. 2021, 19, 178–191. [Google Scholar] [CrossRef]
- Lefnaoui, S.; Moulai-Mostefa, N. Polyelectrolyte Complex Based on Carboxymethyl-Kappa-Carrageenan and Eudragit RL 30D as Prospective Carriers for Sustained Drug Delivery. Chem. Eng. Res. Des. 2015, 97, 165–174. [Google Scholar] [CrossRef]
- Suri, S.; Ruan, G.; Winter, J.; Schmidt, C.E. Microparticles and Nanoparticles. In Biomaterials Science; Elsevier: Amsterdam, The Netherlands, 2013; pp. 360–388. [Google Scholar]
- Kohane, D.S. Microparticles and Nanoparticles for Drug Delivery. Biotechnol. Bioeng. 2007, 96, 203–209. [Google Scholar] [CrossRef] [PubMed]
- Poncelet, D. Microencapsulation: Fundamentals, Methods and Applications. In Proceedings of the Surface Chemistry in Biomedical and Environmental Science; Springer: Berlin/Heidelberg, Germany, 2006; pp. 23–34. [Google Scholar]
- Kilicarslan, M.; Ilhan, M.; Inal, O.; Orhan, K. Preparation and Evaluation of Clindamycin Phosphate Loaded Chitosan/Alginate Polyelectrolyte Complex Film as Mucoadhesive Drug Delivery System for Periodontal Therapy. Eur. J. Pharm. Sci. 2018, 123, 441–451. [Google Scholar] [CrossRef]
- Jurić, S.; Đermić, E.; Topolovec-Pintarić, S.; Bedek, M.; Vinceković, M. Physicochemical Properties and Release Characteristics of Calcium Alginate Microspheres Loaded with Trichoderma Viride Spores. J. Integr. Agric. 2019, 18, 2534–2548. [Google Scholar] [CrossRef]
- Wu, Y.; Zhang, W.; Huang, J.; Luo, Z.; Li, J.; Wang, L.; Di, L. Mucoadhesive Improvement of Alginate Microspheres as Potential Gastroretentive Delivery Carrier by Blending with Bletilla Striata Polysaccharide. Int. J. Biol. Macromol. 2020, 156, 1191–1201. [Google Scholar] [CrossRef]
- Kumar, A.; Rao, K.M.; Han, S.S. Application of Xanthan Gum as Polysaccharide in Tissue Engineering: A Review. Carbohydr. Polym. 2018, 180, 128–144. [Google Scholar] [CrossRef]
- Fuwa, M.; Nakanishi, Y.; Moritaka, H. Effect of Xanthan Gum on Blood Sugar Level after Cooked Rice Consumption. Food Sci. Technol. Res. 2016, 22, 117–126. [Google Scholar] [CrossRef]
- Paquin, J.; Bédard, A.; Lemieux, S.; Tajchakavit, S.; Turgeon, S.L. Effects of Juices Enriched with Xanthan and β-Glucan on the Glycemic Response and Satiety of Healthy Men. Appl. Physiol. Nutr. Metab. 2013, 38, 410–414. [Google Scholar] [CrossRef]
- Bretnall, A.E.; Clarke, G.S. Metformin Hydrochloride. Anal. Profiles Drug Subst. Excip. 1998, 25, 243–293. [Google Scholar]
- Sharma, V.K.; Bhattacharya, A. Release Kinetics of Metformin Hydrochloride Microencapsulated in Isabgol Husk and Sagu Starch Hydrophilic Matrix. Indian Drugs 2009, 46, 860. [Google Scholar]
- Duranteau, L.; Lefevre, P.; Jeandidier, N.; Simon, T.; Christin-Maitre, S. Rôle de La Metformine Dans Le SOPK. In Proceedings of the Annales d’Endocrinologie; Elsevier: Amsterdam, The Netherlands, 2010; Volume 71, pp. e27–e32. [Google Scholar]
- De, A.; Wadhwani, A.; Roychowdhury, P.; Kang, J.H.; Ko, Y.T.; Kuppusamy, G. WZB117 Decorated Metformin-Carboxymethyl Chitosan Nanoparticles for Targeting Breast Cancer Metabolism. Polymers 2023, 15, 976. [Google Scholar] [CrossRef] [PubMed]
- Brayfield, A. Martindale: The Complete Drug Reference. In Health Sciences Books; PHP: London, UK, 2014; ISBN 0-85711-139-6. [Google Scholar]
- Cetin, M.; Sahin, S. Microparticulate and Nanoparticulate Drug Delivery Systems for Metformin Hydrochloride. Drug Deliv. 2016, 23, 2796–2805. [Google Scholar] [CrossRef]
- Kumar, A.; Balakrishna, T.; Rajiv, J. Formulation and Evaluation of Mucoadhesive Microcapsules of Metformin HCl with Gum Karaya. Int. J. Pharm. Pharm. Sci. 2011, 3, 150–155. [Google Scholar]
- Nath, B.; Nath, L.K.; Mazumdar, B.; Sharma, N.; Sarkar, M. Design and Development of Metformin HCl Floating Microcapsules Using Two Polymers of Different Permeability Characteristics. Int. J. Pharm. Sci. Nanotechnol. 2009, 2, 627–637. [Google Scholar] [CrossRef]
- Da Silva, T.S.; Silva, D.A.K.; Nogueira, A.L. Metformin Hydrochloride Sustained Release Biopolymeric System Composed by PLLA-CMC Microparticles. J. Appl. Polym. Sci. 2021, 138, 50806. [Google Scholar] [CrossRef]
- Azzaz, A.A.; Jellali, S.; Akrout, H.; Assadi, A.A. Latifa Bousselmi, Dynamic investigations on cationic dye desorption from chemically modified lignocellulosic material using a low-cost eluent: Dye recovery and anodic oxidation efficiencies of the desorbed solutions. J. Clean. Prod. 2018, 201, 28–38. [Google Scholar] [CrossRef]
- Banerjee, P.; Deb, J.; Roy, A.; Ghosh, A.; Chakraborty, P. Fabrication and Development of Pectin Microsphere of Metformin Hydrochloride. Int. Sch. Res. Not. 2012, 2012, 230621. [Google Scholar] [CrossRef]
- Madsen, K.D.; Sander, C.; Baldursdottir, S.; Pedersen, A.M.L.; Jacobsen, J. Development of an Ex Vivo Retention Model Simulating Bioadhesion in the Oral Cavity Using Human Saliva and Physiologically Relevant Irrigation Media. Int. J. Pharm. 2013, 448, 373–381. [Google Scholar] [CrossRef]
- Hariyadi, D.M.; Pathak, Y.; Hendradi, E.; Erawati, T.; Hidayah, I.; Santos, E. Formulation of Metformin-Loaded Alginate Microspheres by Ionotropic Gelation-Aerosolization Technique. Sains Malays. 2020, 49, 2513–2525. [Google Scholar] [CrossRef]
- Noreen, S.; Hasan, S.; Ghumman, S.A.; Anwar, S.; Gondal, H.Y.; Batool, F.; Noureen, S. Formulation, Statistical Optimization, and In Vivo Pharmacodynamics of Cydonia oblonga Mucilage/Alginate Mucoadhesive Microspheres for the Delivery of Metformin HCl. ACS Omega 2023, 8, 5925–5938. [Google Scholar] [CrossRef]
- Nethaji, R.; Narayanan, A.; Palanivelu, M.; Surendiran, N.S.; Ganesan, B. Formulation and evaluation of metformin hydrochloride loaded mucoadhesive microspheres. Int. J. Pharm. Chem. Biol. Sci. 2016, 6, 124–132. [Google Scholar]
- Gadziński, P.; Froelich, A.; Jadach, B.; Wojtyłko, M.; Tatarek, A.; Białek, A.; Krysztofiak, J.; Gackowski, M.; Otto, F.; Osmałek, T. Ionotropic Gelation and Chemical Crosslinking as Methods for Fabrication of Modified-Release Gellan Gum-Based Drug Delivery Systems. Pharmaceutics 2023, 15, 108. [Google Scholar] [CrossRef]
- Masood, N. F Formulation and In Vitro Characterization of Xanthan Gum/Eudragit Controlled Release Hydrogel Using Metformin as a Model Drug. Pak-Euro J. Med. Life Sci. 2022, 5, 81–92. [Google Scholar] [CrossRef]
- Ray, R.; Maity, S.; Mandal, S.; Chatterjee, T.K.; Sa, B. Development and Evaluation of a New Interpenetrating Network Bead of Sodium Carboxymethyl Xanthan and Sodium Alginate. Pharmacol. Pharm. 2010, 1, 9. [Google Scholar] [CrossRef]
- Patel, J.; Maiti, S.; Moorthy, N.H.N. Repaglinide-Laden Hydrogel Particles of Xanthan Gum Derivatives for the Management of Diabetes. Carbohydr. Polym. 2022, 287, 119354. [Google Scholar] [CrossRef]
- Giri, T.K.; Choudhary, C.; Alexander, A.; Badwaik, H.; Tripathy, M.; Tripathi, D.K. Sustained Release of Diltiazem Hydrochloride from Cross-Linked Biodegradable IPN Hydrogel Beads of Pectin and Modified Xanthan Gum. Indian J. Pharm. Sci. 2013, 75, 619. [Google Scholar] [PubMed]
- Deshmukh, R.; Harwansh, R.K.; Paul, S.D.; Shukla, R. Controlled Release of Sulfasalazine Loaded Amidated Pectin Microparticles through Eudragit S 100 Coated Capsule for Management of Inflammatory Bowel Disease. J. Drug Deliv. Sci. Technol. 2020, 55, 101495. [Google Scholar] [CrossRef]
- Revision, U.S.P.C.C. of United States Pharmacopeia, the National Formulary; United States Pharmacopeial Convention, Inc.: North Bethesda, MD, USA, 2008.
- Ahuja, M.; Kumar, A.; Singh, K. Synthesis, Characterization and in Vitro Release Behavior of Carboxymethyl Xanthan. Int. J. Biol. Macromol. 2012, 51, 1086–1090. [Google Scholar] [CrossRef] [PubMed]
- Yahoum, M.M.; Moulai-Mostefa, N.; Le Cerf, D. Synthesis, Physicochemical, Structural and Rheological Characterizations of Carboxymethyl Xanthan Derivatives. Carbohydr. Polym. 2016, 154, 267–275. [Google Scholar] [CrossRef] [PubMed]
- Sara, H.; Yahoum, M.M.; Lefnaoui, S.; Abdelkader, H.; Moulai-Mostefa, N. New Alkylated Xanthan Gum as Amphiphilic Derivatives: Synthesis, Physicochemical and Rheological Studies. J. Mol. Struct. 2020, 1207, 127768. [Google Scholar] [CrossRef]
- Toumi, S.; Yahoum, M.M.; Lefnaoui, S.; Hadjsadok, A. Synthesis and Physicochemical Evaluation of Octenylsuccinated Kappa-Carrageenan: Conventional versus Microwave Heating. Carbohydr. Polym. 2022, 286, 119310. [Google Scholar] [CrossRef] [PubMed]
- Chogan, F.; Mirmajidi, T.; Rezayan, A.H.; Sharifi, A.M.; Ghahary, A.; Nourmohammadi, J.; Kamali, A.; Rahaie, M. Design, Fabrication, and Optimization of a Dual Function Three-Layer Scaffold for Controlled Release of Metformin Hydrochloride to Alleviate Fibrosis and Accelerate Wound Healing. Acta Biomater. 2020, 113, 144–163. [Google Scholar] [CrossRef]
- Toumi, S.; Yahoum, M.M.; Lefnaoui, S.; Hadjsadok, A. Synthesis, Characterization and Potential Application of Hydrophobically Modified Carrageenan Derivatives as Pharmaceutical Excipients. Carbohydr. Polym. 2021, 251, 116997. [Google Scholar] [CrossRef] [PubMed]
- Singhvi, G.; Hans, N.; Shiva, N.; Dubey, S.K. Xanthan Gum in Drug Delivery Applications. In Natural Polysaccharides in Drug Delivery and Biomedical Applications; Elsevier: Amsterdam, The Netherlands, 2019; pp. 121–144. [Google Scholar]
- Kalpna, M.; Dev, D.; Shahnaz, M.; Parkash, J.; Prasad, D.N. Preparation of Controlled Release Metformin Hydrochloride Loaded Chitosan Microspheres and Evalaution of Formulation Parameters. J. Drug Deliv. Ther. 2018, 8, 378–387. [Google Scholar] [CrossRef]
- Schulte, J.; Stöckermann, M.; Gebhardt, R. Influence of PH on the Stability and Structure of Single Casein Microparticles. Food Hydrocoll. 2020, 105, 105741. [Google Scholar] [CrossRef]
- Khonsari, F.; Zakeri-Milani, P.; Jelvehgari, M. Formulation and Evaluation of In-Vitro Characterization of Gastic-Mucoadhesive Microparticles/Discs Containing Metformin Hydrochloride. Iran. J. Pharm. Res. 2014, 13, 67. [Google Scholar] [PubMed]
- Ray, S.; Banerjee, S.; Maiti, S.; Laha, B.; Barik, S.; Sa, B.; Bhattacharyya, U.K. Novel Interpenetrating Network Microspheres of Xanthan Gum–Poly (Vinyl Alcohol) for the Delivery of Diclofenac Sodium to the Intestine—In Vitro and in Vivo Evaluation. Drug Deliv. 2010, 17, 508–519. [Google Scholar] [CrossRef] [PubMed]
- Bhattacharya, S.S.; Mazahir, F.; Banerjee, S.; Verma, A.; Ghosh, A. Preparation and in Vitro Evaluation of Xanthan Gum Facilitated Superabsorbent Polymeric Microspheres. Carbohydr. Polym. 2013, 98, 64–72. [Google Scholar] [CrossRef]

| Ingredients | F1 | F2 | F3 | F4 |
|---|---|---|---|---|
| MTH (G) | 1 | 1 | 1 | 1 |
| XG (%) | 0.5 | 0.75 | 1 | 1.25 |
| ALCL3 (%) | 5 | 5 | 5 | 5 |
Disclaimer/Publisher’s Note: The statements, opinions and data contained in all publications are solely those of the individual author(s) and contributor(s) and not of MDPI and/or the editor(s). MDPI and/or the editor(s) disclaim responsibility for any injury to people or property resulting from any ideas, methods, instructions or products referred to in the content. |
© 2023 by the authors. Licensee MDPI, Basel, Switzerland. This article is an open access article distributed under the terms and conditions of the Creative Commons Attribution (CC BY) license (https://creativecommons.org/licenses/by/4.0/).
Share and Cite
Yahoum, M.M.; Toumi, S.; Tahraoui, H.; Lefnaoui, S.; Kebir, M.; Amrane, A.; Assadi, A.A.; Zhang, J.; Mouni, L. Formulation and Evaluation of Xanthan Gum Microspheres for the Sustained Release of Metformin Hydrochloride. Micromachines 2023, 14, 609. https://doi.org/10.3390/mi14030609
Yahoum MM, Toumi S, Tahraoui H, Lefnaoui S, Kebir M, Amrane A, Assadi AA, Zhang J, Mouni L. Formulation and Evaluation of Xanthan Gum Microspheres for the Sustained Release of Metformin Hydrochloride. Micromachines. 2023; 14(3):609. https://doi.org/10.3390/mi14030609
Chicago/Turabian StyleYahoum, Madiha Melha, Selma Toumi, Hichem Tahraoui, Sonia Lefnaoui, Mohammed Kebir, Abdeltif Amrane, Aymen Amin Assadi, Jie Zhang, and Lotfi Mouni. 2023. "Formulation and Evaluation of Xanthan Gum Microspheres for the Sustained Release of Metformin Hydrochloride" Micromachines 14, no. 3: 609. https://doi.org/10.3390/mi14030609
APA StyleYahoum, M. M., Toumi, S., Tahraoui, H., Lefnaoui, S., Kebir, M., Amrane, A., Assadi, A. A., Zhang, J., & Mouni, L. (2023). Formulation and Evaluation of Xanthan Gum Microspheres for the Sustained Release of Metformin Hydrochloride. Micromachines, 14(3), 609. https://doi.org/10.3390/mi14030609

